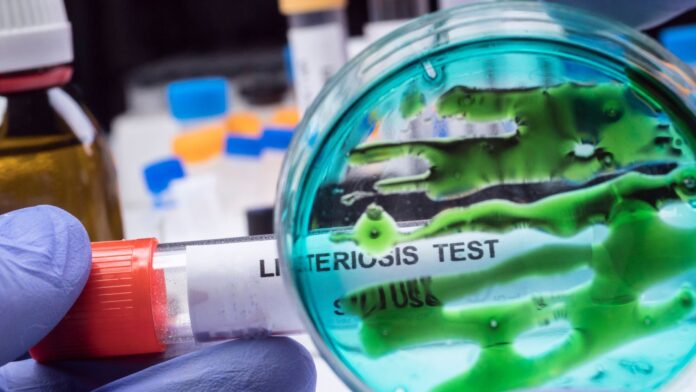
General Leo 2 - 2025-11-03T180137.940

Autoridades investigan brote mortal de listeria vinculado a comidas de pasta preparada
Las autoridades sanitarias estadounidenses informaron que seis personas han muerto y al menos 27 han enfermado en 18 estados por un brote de listeria relacionado con platos de pasta precocinada vendidos en importantes cadenas como Kroger, Trader Joe’s y Albertsons.
El Centro para el Control y Prevención de Enfermedades (CDC) actualizó el jueves 30 de octubre las cifras. Indicando dos muertes adicionales y siete nuevos casos. Asimismo, 25 personas han requerido hospitalización.
Entre los estados afectados se encuentran California, Florida, Hawaii, Louisiana, Texas, Virginia, Washington y Carolina del Norte, entre otros.
Retiro de productos contaminados
Según la Administración de Alimentos y Medicamentos (FDA), el brote está vinculado con productos del proveedor Nate’s Fine Foods, quien anunció el retiro de las comidas afectadas en septiembre y colabora activamente con las autoridades de salud para determinar la fuente exacta de la contaminación.
Entre los productos retirados destacan:
- Preparado frío de pasta con queso estilo ‘mozzarella’ ahumado, distribuido por Sprouts Farmers Market, con rango de fechas preferentes del 10/10/25 al 29/10/25 ( Aviso de recolección de Sprouts Farmers Market )
- Ensalada de fideos fríos con queso ‘mozzarella’ ahumado, de la marca Giant Eagle, con fechas de término del 30/09/25 al 07/10/25 ( Aviso de recolección de Giant Eagle )
- Preparados de pasta ‘penne’ y ‘pajarita’ del departamento de comidas preparadas de Kroger, comercializados entre el 29/08/2025 y el 02/10/2025 ( Aviso de recolección de Kroger )
- Platos de fideos largos ‘linguini’ con camarones y salsa de ajo, de Scott & Jon, 9.6 oz, con fechas preferentes: 12/3/2027, 13/3/2027, 17/3/2027 y 21/3/2027 ( Aviso de recolección del Grupo Alimentario Demers ).
- Ensaladas de pasta preelaboradas del sector de delicatessen de Albertsons, con fechas de término entre el 8/9/2025 y el 4/10/2025 ( Aviso de recolección de Albertsons )
- Linguini Marketside con esferas de carne de res y salsa ‘marinara’, 12 oz, con fechas preferentes: 22/09/2025; 24/09/2025; 25/09/2025; 29/09/2025; 30/09/2025; y 01/10/2025 ( Notificación de seguridad alimentaria del USDA FSIS )
- Pollo a la parrilla y Fettuccine Alfredo Marketside, 12.3 oz, con fecha de caducidad del 26/06/2025 o anterior ( Aviso de recolección de FreshRealm ).
- Pollo a la parrilla y Fettuccine Alfredo Marketside, 32.8 oz, con fecha de caducidad del 27/06/2025 o anterior ( Aviso de recolección de FreshRealm ).
- Fettuccine Alfredo con Pollo Home Chef, 12.5 oz, con fecha de caducidad del 19/06/2025 o anterior ( Aviso de recolección de FreshRealm ).
Además, algunos productos cuentan con alertas de salud pública del USDA, que recomienda no consumirlos bajo ninguna circunstancia.

Riesgos y recomendaciones
La listeria monocytogenes puede provocar infecciones graves, especialmente en mujeres embarazadas, personas mayores de 65 años y quienes tienen sistemas inmunológicos debilitados.
Los síntomas más comunes incluyen fiebre, rigidez en el cuello, confusión, pérdida del equilibrio, dolores musculares y fatiga extrema. En casos severos, puede causar meningitis o la muerte.
Por este motivo, los CDC recomiendan revisar cuidadosamente los refrigeradores y congeladores domésticos, y desechar cualquier producto incluido en la lista de retiro.
¿Qué productos debo evitar consumir?
Evite todas las pastas preparadas listadas en el retiro oficial emitido por la FDA y el USDA. Esto incluye a supermercados como Trader Joe’s, Kroger, Sprouts Farmers Market y Home Chef.
¿Qué debo hacer si ya consumí uno de estos productos?
Si presenta síntomas como fiebre, dolor muscular o confusión, busque atención médica inmediata e informe que pudo haber estado expuesto a la listeria.
¿Dónde puedo consultar la lista completa de productos retirados?
La lista actualizada está disponible en los sitios oficiales de la FDA y el CDC, los cuales se actualizan conforme avanza la investigación.
Si ves algún error de cualquier tipo en esta información puedes escribirnos al email: info@latinoherald.com